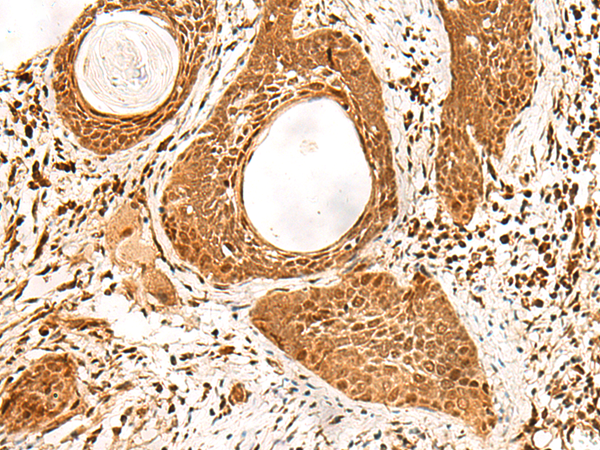

-
分类: 科研抗体货号: P09906别名: DDX2B; EIF4A; EIF4F; BM-010; eIF4A-II; eIF-4A-II应用: WB,IHC反应种属: Human, Mouse, Rat
-
分类: 科研抗体货号: P09905别名: EIF-2B; EIF2Bgamma应用: IHC反应种属: Human, Rat
-
分类: 科研抗体货号: P09924别名: PD2; F23149_1应用: IHC反应种属: Human, Mouse, Rat
-
分类: 科研抗体货号: P09904别名: PSP1应用: IHC反应种属: Human, Mouse, Rat
-
分类: 科研抗体货号: P09923别名:应用: WB反应种属: Human, Mouse, Rat
-
分类: 科研抗体货号: P09903别名: CTLH; GID2; RMD5; GID2A; p44CTLH应用: IHC反应种属: Human, Mouse
-
分类: 科研抗体货号: P09922别名: IEF-SSP-9502应用: IHC反应种属: Human, Mouse
-
分类: 科研抗体货号: P09902别名: LDPL应用: IHC反应种属: Human, Mouse, Rat
-
分类: 科研抗体货号: P09907别名: ARM1; ARM-1; GP110应用: IHC反应种属: Human, Mouse, Rat
-
分类: 科研抗体货号: P09921别名: EXDL2; C14orf114应用: WB,IHC反应种属: Human, Mouse

鄂公网安备42018502007531号
鄂公网安备42018502007531号

